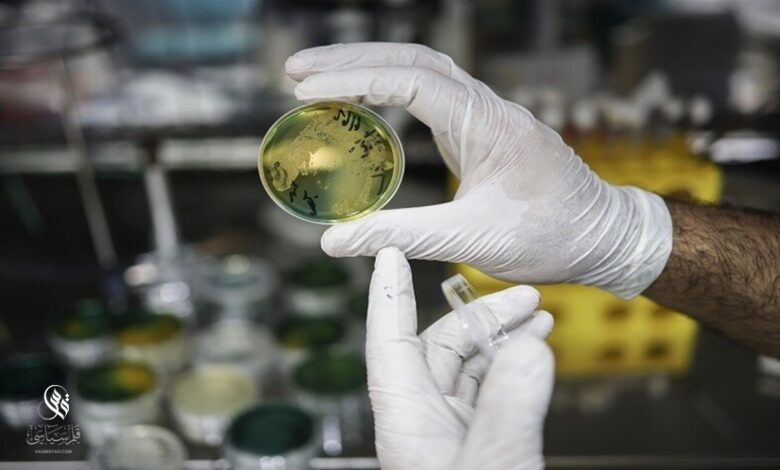

إرتفاع حالات الإصابة بالكوليرا حول العالم
شهد العام 2023 ارتفاعا قياسيا بحالات الإصابة بالكوليرا، فوفقا للبيانات الأولية الصادرة عن منظمة الصحة العالمية أصاب المرض أكثر من 667 ألف شخص على مستوى العالم توفي منهم 4000 مريض.
وصنفت منظمة الصحة العالمية عودة ظهور الكوليرا على مستوى العالم كحالة طوارئ من الدرجة الثالثة، وهو أعلى مستوى للطوارئ الصحية الداخلية.
وكان تفشي المرض الأكثر حدة في مالاوي بإفريقيا وهايتي في البحر الكاريبي، حيث وصل عدد الوفيات إلى 1771 و1156 على التوالي، مما يجعله أسوأ تفش للوباء في تاريخ مالاوي.
وقالت ماتشيندا مارونغوي مديرة برنامج “أوكسفام” في جنوب إفريقيا: “إن المعدل غير المسبوق للحالات والوفيات مرعب ويرهق الأنظمة الصحية في هذه البلدان”.
والكوليرا مرض بكتيري ينتشر عن طريق المياه والأغذية الملوثة، ويسبب الإسهال الشديد والقيء.
ونظرا لانتشار المرض في بلدان جديدة والنقص العالمي في لقاحات الكوليرا، قالت منظمة الصحة العالمية إنها واصلت تقييم مستوى خطر المرض على أنه “مرتفع للغاية”.



